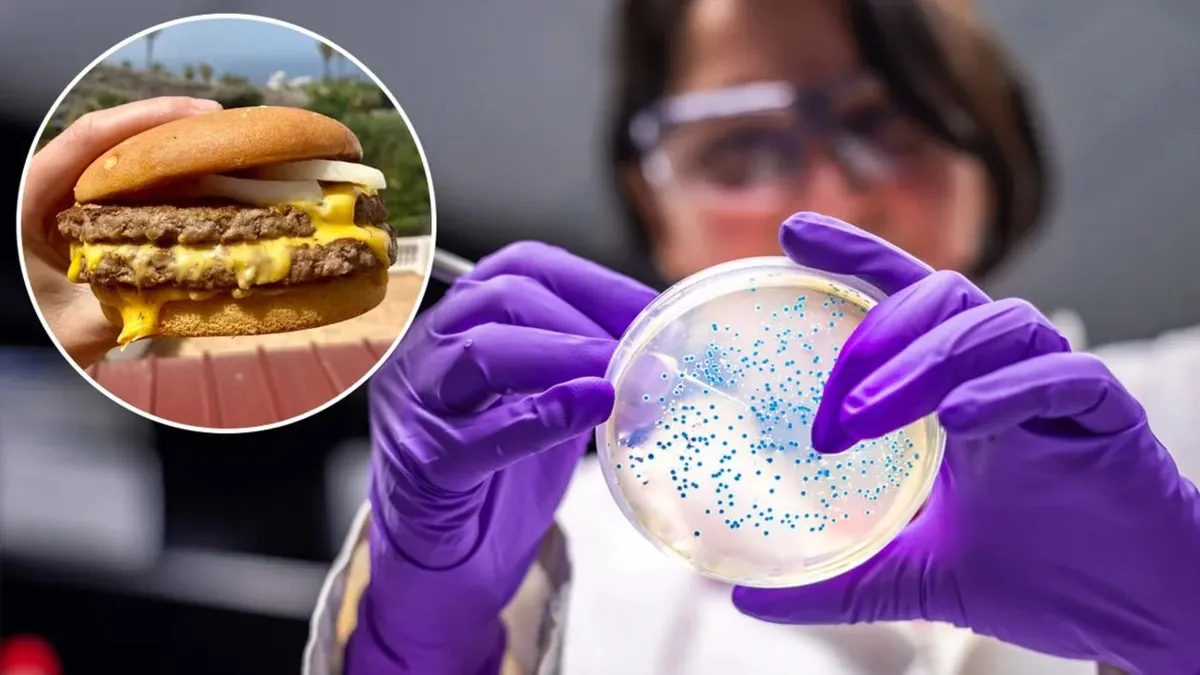
ABD’yi saran McDonald’s salgınında yeni gelişme: Koli basili alarmı sona erdi ABD’yi saran McDonald’s salgınında yeni gelişme: Koli basili alarmı sona erdi

ABC News’ün haberine göre, ABD Hastalık Kontrol ve Önleme Merkezi (CDC), koli basili “salgınında” toplam 104 kişinin hastalandığını açıkladı. CDC’nin açıklamasında, 14 eyalete yayılan salgında hastalananların test yaptırmadığına, hastalanan kişi sayısının 104 kişiden fazla olabileceğine işaret edildi.
Koli basili salgının sona erdiği duyurulan açıklamada, bu kapsamda en fazla vakanın 30 kişiyle Colorado eyaletinde görüldüğü ve 1 kişinin yaşamını yitirdiği aktarıldı.
ABD Gıda ve İlaç Dairesi (FDA) ise yaptığı açıklamada, McDonald’s’ın söz konusu bakterinin tespit edildiği soğanları servis etmediğini vurgulayarak “bu salgınla ilgili devam eden bir gıda güvenliği endişesi görünmediğini ve konuya dair başlatılan soruşturmanın da artık kapandığını” kaydetti.
Hamburgerlerde kullanılan sığır etinden yapılan köfte ve soğanın koli basili bakterisi içerebileceği ancak bunun kesin olmadığı belirtilen açıklamada, McDonald’s’ın bazı eyaletlerde bu hamburgerlerin satışını ve şüpheli malzemelerin kullanımını durdurduğu ifade edilmişti. Öte yandan, McDonald’s ise Quarter Pounder’ı çok sayıda eyaletteki menülerden tamamen kaldırmıştı.


















